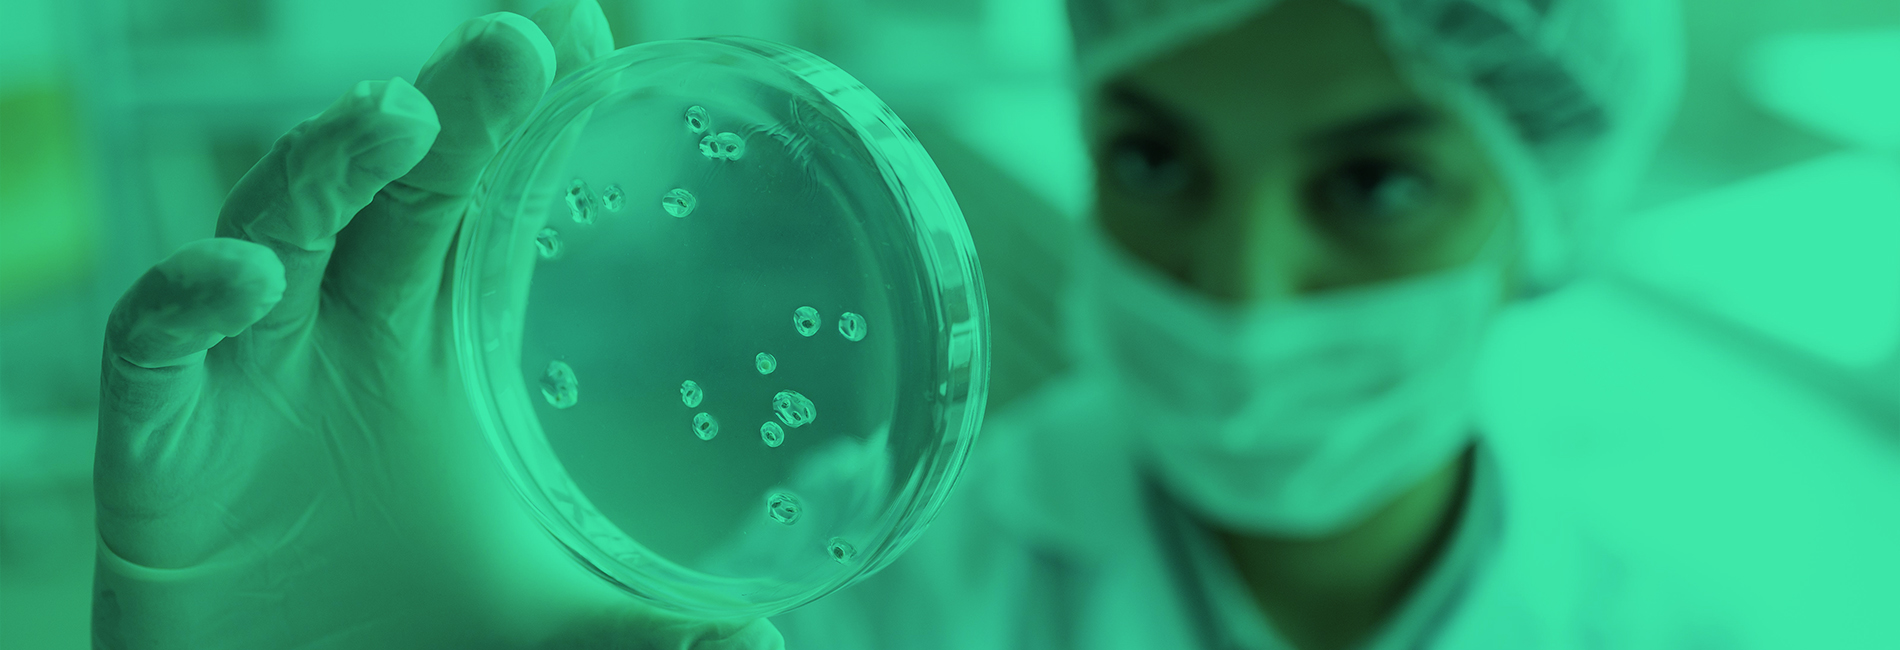
header_slide/Header_trScoh3.jpg

Jordan David - Chembo Bevil
Head of Sales Chembo Bevil - Tournai
« Partant du constat que les détergents prêts à l’emploi contiennent jusqu’à 95 % d’eau et que près de 250 millions d’emballages à usage unique finissent chaque année à la poubelle, nous voulions trouver un concept écoresponsable qui répondait également à une préoccupation croissante de nombreux consommateurs. La solution se devait d’être efficace, pratique, économique et surtout écologique (empreinte carbone réduite à son maximum). Nous avons confié le projet à R&O Lab qui a développé un concept de nettoyants en poudre à diluer dans l'eau de distribution et qui permettait au consommateur de reconstituer lui-même son détergent. Quant au choix des packagings, il s’est porté sur des sachets en papier recyclable contenant le dosage correct de poudre et des flacons réutilisables. Déclinés en nettoyants multi-surfaces, détartrant et dégraissant, les sachets de poudre Epur sont certifiés Ecocert. En outre, notre concept Epur a obtenu le Trophée d’Or au concours Natexpo 2022. Tout ceci n’aurait pas été possible sans la précieuse collaboration de R&O Lab. »
Anaëlle Kovacs - Baxter
Technicienne microbio chez Baxter
" J'ai réalisé mon stage de dernière année Bachelier et mon travail de fin d'études chez R&O lab. L'équipe est extraordinaire, chacun est impliqué dans le travail et une ambiance agréable règne dans l'ensemble des bureaux ce qui en fait une entreprise très accueillante.
On m'a donné l'opportunité de m'intégrer dans la routine du laboratoire. De mon côté, j'ai pu apporter un peu de mon savoir grâce au sujet de mon TFE qui portait sur une recherche de méthode de quantification enzymatique sur les différentes enzymes présentes dans les produits de nettoyage bioenzymatiques. J'ai beaucoup appris pendant mon passage chez R&O Lab et j'ai rencontré des personnes formidables. "
JF Eloin & A. Pirson - LaverVert
Gérant LaverVert - Namur
« Porteur du projet de fabriquer nos propres produits ménagers à base d’ingrédients naturels et locaux, il était indispensable de trouver un laboratoire spécialisé en R&D. L’étroite collaboration avec R&O Lab, nous a permis de valider et d’optimiser toutes nos formulations. Les plus-values de la collaboration furent indéniablement leur expertise, leur expérience et surtout l’accompagnement tout au long du processus. Sans compétences particulières en chimie, nous avons également apprécié leur capacité à vulgariser les explications fournies. Nos idées fusent pour une nouvelle collaboration avec eux. »
Home Care Products Group Manager - Henkel
Laundry & Home Care - Henkel France
"Henkel France avait comme projet de développer un nettoyant ménager à base d’ingrédients bruts et plus exactement de savon noir. Or, les exigences de qualité étant élevées chez Henkel, il nous fallait collaborer avec un laboratoire expérimenté en R&D comme R&O Lab. Ce fut un véritable travail d’équipes durant toutes les phases du développement (formulation, packaging, tests de performance,…). Cependant, c’est surtout grâce à leur professionnalisme, leur disponibilité et à leur hyper réactivité, que notre produit ménager à base de savon noir a réussi les tests Henkel. »